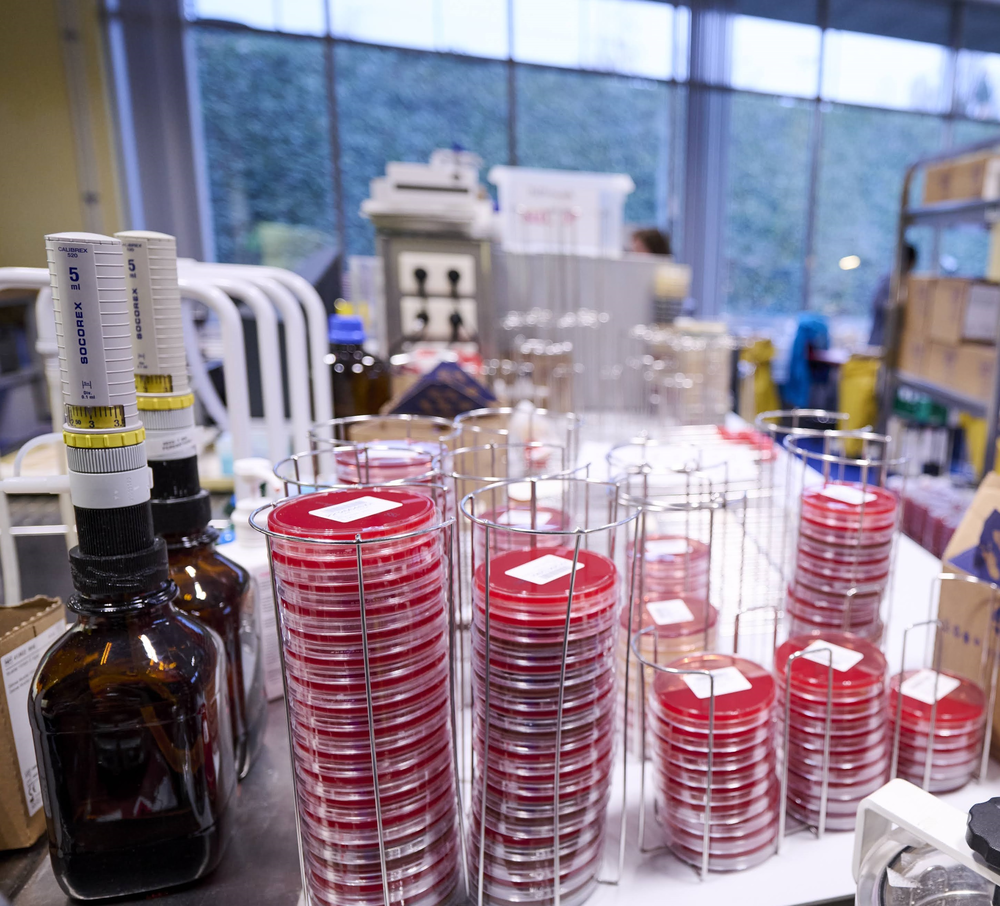

Service des Maladies infectieuses et tropicales
Les maladies infectieuses sont causées par des micro-organismes pathogènes comme les bactéries, les virus, les parasites ou les champignons. Elles peuvent se transmettre par l’environnement ou par contact entre individus, favorisant leur circulation au sein des collectivités. Grâce aux avancées médicales (vaccins et antibiotiques), certaines de ces maladies ont pu être éradiquées.
En bref
Notre Service se réfère à l'infectiologie, qui consiste en l'étude de la prévention, du diagnostic et du traitement des maladies infectieuses.

Spécialités
- Consultations générales : mise au point diagnostique et traitement des maladies infectieuses (infections bactériennes, virales, fongiques, parasitaires, … acquises localement ou à l'étranger), mais aussi des syndromes complexes en lien avec la médecine interne générale (maladies auto-immunes et auto-inflammatoires, certains troubles génétiques, …)
- Consultations de diagnostic et de suivi des personnes vivant avec le VIH
- Dépistage et traitement des Infections Sexuellement Transmissibles
- Prise en charge des infections ostéo-articulaires (pieds diabétiques infectés)
- Consultations "ImmunoStart" (préparation à l’immunosuppression, le patient étant adressé par le médecin prescripteur de l’immunothérapie)
- Clinique du Voyageur : centre de médecine de voyage accueillant les voyageurs avant ou après leur voyages (vaccination, conseils de prévention et dépistages de pathologies tropicales). Ce centre est agréé par le ministère de la Santé
Autres missions
Le Service remplit également d’autres missions au sein de la Citadelle :
- Groupe de gestion des antibiotiques (Antimicrobial Stewardship) : surveillance de la consommation des anti-infectieux et de la résistance aux anti-infectieux, audits, recommandations de bon usage des anti-infectieux, initiatives visant à limiter l'utilisation inappropriée des anti-infectieux, ...
- Hygiène hospitalière (cellule de prévention et contrôle des infections)
- Hospitalisation à domicile
- Gestion des épidémies et des infections nosocomiales
- Nombreux projets pluridisciplinaires : prise en charge de l’échinococcose, « Endocardite Team », « greffe de selle », « VIH », ...
Clinique du Pied diabétique
Clinique du Voyageur
LaboCita - Biologie clinique
Chef de Service

Médecins



Les consultations du Service des Maladies infectieuses et tropicales se déroulent sur le site Citadelle, route 43, et sur le site Laveu, route 355.
Comment bien se préparer avant une consultation ?
Avant de vous rendre en consultation, nous vous demandons de préparer toute une série d'informations et de documents (liste de vos médicaments, vos antécédents, les résultats de vos derniers examens, ...). Nous vous invitons également à lister les questions que vous souhaitez poser au spécialiste rencontré.
Tout savoir sur votre consultation (préparation, déroulement, annulation ou report de rendez-vous)
Vous devez être hospitalisé à l’hôpital de la Citadelle, dans l’unité des Maladies infectieuses et tropicales. Votre chambre sera située en salle 25 (route A220).
Comment se préparer avant une hospitalisation ?
Avant votre hospitalisation, certaines démarches sont nécessaires comme les formalités d’admission et la préparation des documents requis. Anticiper ces étapes permet d’aborder votre séjour plus sereinement.
Ressources médicales




